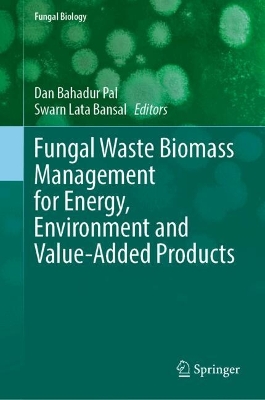
ibs

L’articolo è stato aggiunto alla lista dei desideri
IBS.it, l'altro eCommerce
Fungal Waste Biomass Management for Energy, Environment and Value-Added Products
Cliccando su “Conferma” dichiari che il contenuto da te inserito è conforme alle Condizioni Generali d’Uso del Sito ed alle Linee Guida sui Contenuti Vietati. Puoi rileggere e modificare e successivamente confermare il tuo contenuto. Tra poche ore lo troverai online (in caso contrario verifica la conformità del contenuto alle policy del Sito).
Grazie per la tua recensione!
Tra poche ore la vedrai online (in caso contrario verifica la conformità del testo alle nostre linee guida). Dopo la pubblicazione per te +4 punti
Altre offerte vendute e spedite dai nostri venditori

Tutti i formati ed edizioni
Promo attive (1)
Bioconversion of waste is a natural process aiding in the recovery of resources and biotechnology-facilitated natural recycling processes. Biotechnological treatments to food processing wastes found in large quantities can produce useful end products, such as microbial biomass protein, while wastes are also purified during the process. Fungi as microorganism and as fungal biomass have been used for many applications such as enzyme production for biomedical, biorefinery, and other industries. Additionally, environmental pollution is a crucial problem for the entire world, and it is growing continuously. Continuous growth of pollution is resulting harmful changes like global warming and pollution of air, water, and soil. These changes are directly associated with various activities like uncontrolled agricultural practices, deforestation, urbanization, accumulation of huge amounts of agricultural and food waste, improper dumping of naturally occurred waste and forest residues, etc. Therefore, proper utilization of these wastes may be a better solution for this problem. Fungal-based biomass materials are good sources of carbohydrates, oil & fats, cellulosic content, and other useful chemical components which can be converted into value-added products for production of clean energy, bioenergy, bio-adsorbents, and useful chemicals. This book provides information, processes, and ideas for the conversion of waste into useful and consumable enzymes through biological approaches. Within the last few years, researchers have found that food and agricultural waste biomass have the potential to produce value-added products. Technological information for the production of nutraceuticals and organic acids from the agro-waste are also covered in this book.
L'articolo è stato aggiunto al carrello
Le schede prodotto sono aggiornate in conformità al Regolamento UE 988/2023. Laddove ci fossero taluni dati non disponibili per ragioni indipendenti da IBS, vi informiamo che stiamo compiendo ogni ragionevole sforzo per inserirli. Vi invitiamo a controllare periodicamente il sito www.ibs.it per eventuali novità e aggiornamenti.
Per le vendite di prodotti da terze parti, ciascun venditore si assume la piena e diretta responsabilità per la commercializzazione del prodotto e per la sua conformità al Regolamento UE 988/2023, nonché alle normative nazionali ed europee vigenti.
Per informazioni sulla sicurezza dei prodotti, contattare productsafetyibs@feltrinelli.it
L’articolo è stato aggiunto alla lista dei desideri

